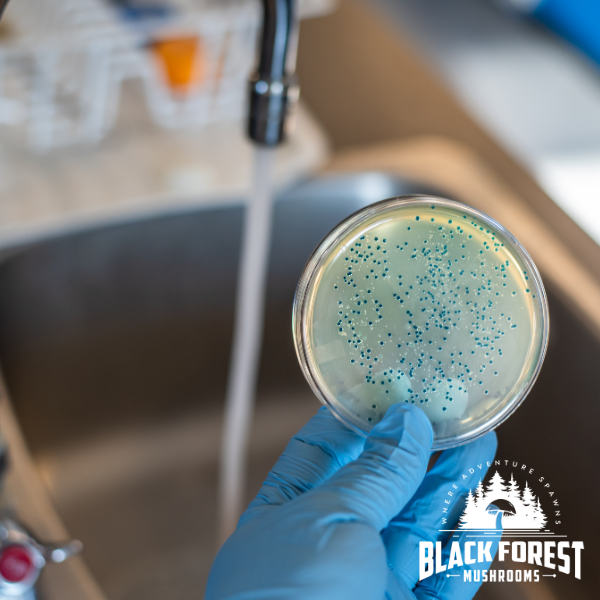

How to Avoid Contamination in Mushroom Cultivation
Contamination is one of the biggest challenges in mushroom cultivation, but with the right practices and tools, it’s manageable. Maintaining a sterile environment is key to growing healthy mushrooms and avoiding common pitfalls. Use this guide as a reference to minimize contamination risks throughout your cultivation journey.
Suggested Materials
- Laminar Flow Hood (if available) – Provides a sterile air environment.
- Still Air Box (SAB) – A low-tech alternative for working with sterile materials.
- Isopropyl Alcohol (70% or higher) – For cleaning tools, gloves, and surfaces.
- Gloves – To maintain sterility during every step of the process.
- Face Mask – To prevent airborne contaminants from affecting your grow.
- Trailblazer’s Grain Bag – Pre-sterilized grain bag to start your culture.
- Forest’s Bounty All-in-One Grow Bag or Forest Floor Substrate Bag – Final substrates for colonization.
- Clean Knife or Scissors – For cutting open bags or trimming substrate.
- Bag Sealer – For resealing bags if needed.
- Incubator or Clean Storage Space – Ensure consistent temperatures for incubation.
Best Practices for Avoiding Contamination
-
Work in a Clean, Sterile Environment
Whenever possible, use a laminar flow hood to create a sterile workspace. If a hood isn’t available, a Still Air Box (SAB) is a simple and effective alternative. -
Prepare Yourself and Your Workspace
Shower before starting work, wash your hands and forearms thoroughly, and wear gloves, clean clothes, and a face mask. Wipe down all surfaces and tools with isopropyl alcohol and allow them to dry completely. -
Inspect All Materials Before Use
Always check your grain spawn and liquid culture for signs of contamination, such as off-colors or foul odors. Only use materials from trusted sources like Black Forest Mushrooms to ensure they are properly sterilized. -
Use Sterile Tools and Techniques
Clean tools with isopropyl alcohol before and after each use. Avoid breathing or talking directly over open bags, and be mindful not to touch the inside of containers or bags to prevent introducing contaminants. -
Secure and Store Your Grow Bags Properly
Use a bag sealer to reseal any opened bags. Place bags in a clean, dark area or incubator with good fresh air exchange (FAE). Maintain temperatures between 55-75°F (around 70°F is ideal). -
Embrace Contamination as Part of the Learning Process
Even with the best practices, contamination may still occur. View it as part of the cultivation journey—it helps sharpen your skills and makes your successes even more rewarding.
Disclaimer
The information provided in this guide is intended for safe and sterile gourmet mushroom cultivation. Always handle tools and materials with care to prevent contamination and injury. Black Forest Mushrooms supplies quality materials and best practices, but contamination risks can still occur due to environmental factors. Follow proper sterilization protocols to minimize risks and ensure the best results.
Leave a comment